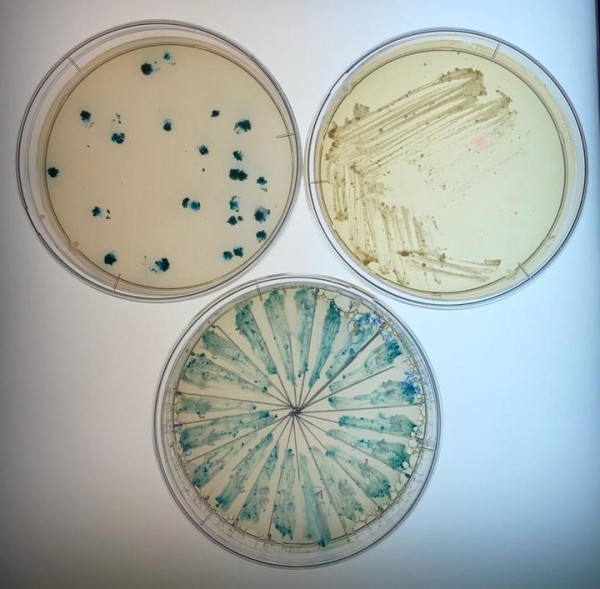
Российские ученые создали суперпатоген: все антибиотики бессильны

Российские ученые создали суперпатоген: все антибиотики бессильны
В «монстра» превратили родственника возбудителя туберкулеза
«Что нас не убивает, делает нас сильнее». Правдивость этой поговорки на практике доказали российские биологи из Института экологии РУДН, Института общей генетики имени Н.И. Вавилова и Башкирского государственного аграрного университета. Фундаментальное исследование процессов образования суперпатогенов привело их к созданию устойчивого к целому ряду антибиотиков микроорганизма. Малыми дозами противомикробных препаратов они превратили в такого «монстра» родственника возбудителя туберкулеза Mycobacterium smegmatis mc2 155, причем, без изменения его ДНК.

Исполнитель проекта по гранту РНФ Шатров П.А., студент ФБМФ МФТИ 4 курса, наносит посевной материал на питательную среду. Источник: Алексей Ватлин
Туберкулез является одним из самых опасных заболеваний в мире. Его возбудитель – микроорганизм Mycobacterium tuberculosis. Как и многие другие патогены, со временем он обретает устойчивость (резистентность) к медицинским препаратам. За эту резистентность отвечает ген whiB7. Чтобы понять механизм ее возникновения, специалисты решили смоделировать для возбудителя патологии «больничные условия», то есть проверить, не являются ли причиной устойчивости те самые лекарства, которыми его пытаются лечить.
В качестве модельного образца исследователи использовали непатогенного родственника возбудителя туберкулеза Mycobacterium smegmatis mc2 155. Их исследование было поддержано Российским научным фондом.
Микобактерию испытывали антибиотиками, которые используются для лечения туберкулеза: канамицином, стрептомицином, офлоксацином и тетрациклином. Пропитанные ими бумажные диски клали в чашки Петри с культурами этой бактерии. Дозы препаратов меняли, а затем сравнивали рост условного патогена с контрольным образцом без антибиотика.
Чашки Петри с исследуемым штаммом M. smegmatis mc2 155. Источник: Алексей Ватлин
Выяснилось, что малые дозы антибиотиков не убивали, а только укрепляли его «иммунитет», то есть, увеличивали активность основного гена-регулятора устойчивости whiB7. Так, ученые наблюдали значительное увеличение сопротивляемости микроорганизма под действием канамицина и офлоксацина. Наибольшая же сопротивляемость появлялась у него при контакте с тетрациклином. Таким образом, малые дозы сразу девяти разновидностей антибиотиков, в состав которых входят вышеназванные вещества, оказались не оружием, а «прививкой» для болезнетворного микроорганизма.
По словам доцента РУДН, кандидата биологических наук Алексея Ватлина, подобные устойчивые микробы могут появляться в окружающей нас среде вследствие неконтролируемого использования антибиотиков в сельском хозяйстве, пищевом и фармацевтическом производствах. При этом, как показали опыты, они не меняют своей ДНК, – новые свойства возникают у них за счет активации генов резистентности.
Изучив механизмы происхождении лекарственной устойчивости, ученые надеются в будущем разработать новые методы борьбы с болезнетворными бактериями.
Источник: www.mk.ru
Комментарии закрыты.